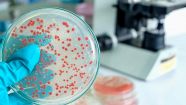

Shopping

Lefant, il robot che aspira, lava e fa tutto da solo: 70% di sconto

Elimina l’effetto unto dai capelli in 1 minuto con 5 euro
DiLei

Jolanda minacciata: "Il corpo, una condanna". Parla Ambra

La Principessa ha una nuova passione che "le fa bene"
Magazine

Patrick Dempsey: dietro l'addio a Grey's Anatomy c'è una verità sconvolgente

Ascolti tv ieri (26 ottobre): super ritorno per Ranucci, De Martino attacca Scotti
DiLei Girlz

Puoi applicare questi 5 blush ad occhi chiusi, fa tendenza

morning routine: diciamo basta all’iperproduttività

TrigNO, dopo Amici canta la ribellione della sua "Ragazzina"

Il bastone smart che aiuta i ciechi a sentirsi più sicuri e autonomi
QF Green

Edison Energia raggiunge 1.100 negozi: cresce la rete green e digitale per famiglie e imprese

In Italia investimento da 50 milioni per gas pulito
Batteri nelle piante italiane: li stanno studiando adesso

L'importanza di un approccio integrato: servizi dalla A alla Z per la tua auto
QuiFinanza

La Guardia di Finanza ora fa controlli a casa: chi rischia

Governo bocciato, potrebbe cambiare tutto per case e banche
Offerte della settimana

256 capsule
Per un caffè buono come al bar, tanti gusti disponibili Lavazza
-46%
Scopri

Frullatore
Con recipiente in vetro, da 1,5 lt, per bevande fresche Ariete
-29%
Scopri

Friggitrice
Per cuocere, arrostire e grigliare senza aggiungere olio Tognana
-53%
Scopri
DiLei Home&Living

Abbattere l'albero condominiale: attenzione a questi aspetti






































































































































































